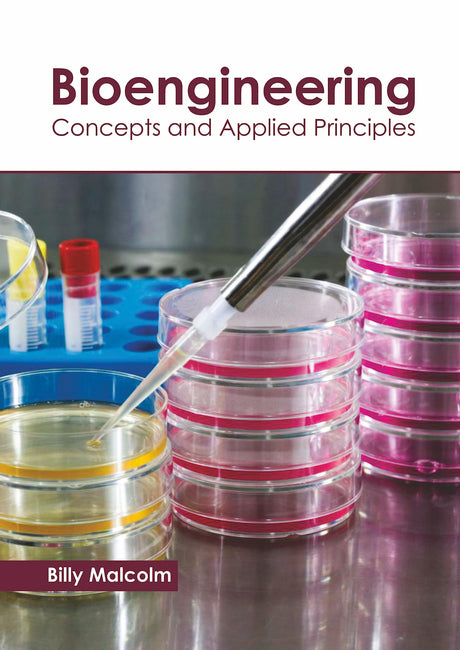
Bioengineering: Concepts and Applied Principles - Retail Maharaj

Shilalekh Publishers
Bharat Ke Chidiyaghar (Awarded)
Sale price Rs.280.00 Regular price Rs.350.00Unit price /UnavailableNational Book Trust
BHARAT KE NAGRIKON KA ADHIKAR (Hindi)
Regular price Rs.18.00Unit price /UnavailableNational Book Trust
Bhartiya Loktantra Aur Ramkatha (Hindi)
Regular price Rs.240.00Unit price /Unavailable- 25% off
McGraw-Hill Education
BIG DATA ANALYTICS, 1ST EDITION
Sale price Rs.683.00 Regular price Rs.910.00Unit price /Unavailable - 25% off
Springer
বায়োইলেকট্রনিক নাক: জৈবপ্রযুক্তি এবং ন্যানোপ্রযুক্তির একীকরণ
Sale price Rs.7,589.00 Regular price Rs.13,799.00Unit price /Unavailable- 45% off
Callisto Reference
জৈবপ্রযুক্তি: একটি আধুনিক পদ্ধতি
Sale price Rs.6,619.00 Regular price Rs.12,035.00Unit price /Unavailable - 45% off
Callisto Reference
জৈবপ্রযুক্তি: ধারণা এবং প্রয়োগিক নীতিমালা
Sale price Rs.6,482.00 Regular price Rs.11,786.00Unit price /Unavailable Encounter Books
জৈববিবর্তন: জৈবপ্রযুক্তি কীভাবে আমাদের বিশ্বকে বদলে দিচ্ছে
Sale price Rs.1,321.00 Regular price Rs.2,402.00Unit price /UnavailablePHI LEARNING PRIVATE LIMITED
Sale price Rs.626.00 Regular price Rs.695.00Unit price /UnavailableELSEVIER
Biomass for Renewable Energy, Fuels, and Chemicals
Sale price Rs.15,300.00 Regular price Rs.20,400.00Unit price /Unavailable- 45% off
Intelliz Press
জৈব পদার্থ এবং ন্যানোবায়োটেকনোলজি
Sale price Rs.6,847.00 Regular price Rs.12,450.00Unit price /Unavailable Springer
জৈব চিকিৎসা প্রয়োগ পলিমার মিশ্রণ: ১৪৯ (পলিমার বিজ্ঞানে অগ্রগতি)
Sale price Rs.4,047.00 Regular price Rs.7,359.00Unit price /Unavailable